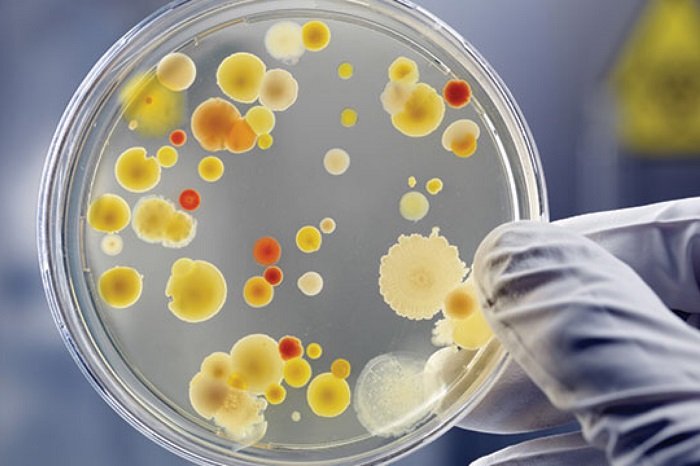

Drug Information

Information About Drugs
We define a drug as any substance other than food and water that, after being administered, affects at least some structures and/or function(s) of a body and/or affects the structures and/or function(s) of a thing or things that affect the body it was administered to.
Essential Everyday Drugs
Thousands of different known drugs exist here and now (herenow). Under the aforementioned definition, even substances that are not utilized to treat diseases, disorder, and/or other adverse health conditions, but that do affect at least some structures and/or functions of a body and can be used to optimize structures and/or function(s) of a body are also considered drugs. We provide two examples of such drugs, which you probably have a deficiency or insufficiency of if you do not regularly dose yourself with the said substances! You may not know that you are operating sub-optimally without the drugs being administered to yourself by yourself or by somebody else, but you may realize that you have been functioning sub-optimally without the drugs after you begin dosing yourself with them as scientific studies have shown us.
Benefits of Proper Drug Use
Functioning improves after these substances are self- or otherwise-administered to self at the particular dosages and frequencies detailed below. In either case, the two drugs that are subsequently mentioned and briefly described have been shown to be beneficial for beings of the genus Homo to utilize by consuming them (regardless of whether or not one has any chronic or other types of diseases, disorders, and/or other types of adverse health conditions). We absolutely promote drug use where and when (“wherewhen”) the use of the drugs is appropriate and leads to benefits that outweigh any associated costs that may be linked to the drugs in question.
Expanding Our Drug Insights
We will continue to develop this section of our website and add information about other drugs as well as the two that we are adding first due to their importance, but for now suffice it to say that the two drugs that will be briefly touched on below have zero or close-to-zero potential “side effects” or costs that anyone can even weigh against the benefits that they have been associated with via many scientific research studies that have been recently published.


Introduction to Creatine
The first drug we will discuss is creatine, which is typically sold, without need for a prescription from a physician, in stores that include Amazon.com and GNC, in a mixture of inert substances known by the name of creatine monohydrate powder.
For a review of evidence on daily creatine self-administration, see (Kreider, R. B. et al., 2025, Frontiers in Nutrition). In short, daily self-administration of creatine in creatine monohydrate powder is safe and beneficial at all stages of life, and provides benefits including supporting brain health (including cognition and memory), preserving muscles, improving cellular energy metabolism, enhancing immune system functioning, improving cardiovascular health, and even slowing down the progression of certain types of cancers.
Recommended Dosage
Creatine Intake
Creatine monohydrate drug deficiency is associated with or causes sub-optimal brain functioning, sub-optimal immune system functioning, increased cardiovascular disease symptoms, rapid progressions of cancers, loss of muscles during aging, negative outcomes in adverse health conditions, including diabetes, sarcopenia, osteoporosis, and neuromuscular diseases.
Everyone, including pregnant and non-pregnant females, males, and beings of the genus Homo of any age from before birth until death, should self-administer or have administered to, creatine as creatine monohydrate powders dissolved in waters, daily.
Recommended dosing involves a “loading phase” of 0.3 grams (g)/kilogram (kg)/day for 7 days, followed by indefinite maintenance doses of 0.05–0.15 g/kg/day. As an example, an average 25 years-aged member of Homo weighing 62 kg (137 pounds (lbs.)) would need approximately 9 grams per day of creatine monohydrate powder after the initial higher-dose “loading phase” dosages.

Psilocybin Practices

Psilocybin Insights
Theoretically, from a neuroscience perspective, even microdosing psilocybin (such as every four days on a repeated cycle) could and probably does lead to some benefits for the brain as the drug, at least at higher doses, has been shown in non-human animal models to cause enhanced neuroplasticity (brain’s ability to form more new connections more quickly), which could support learning and even overcoming maladaptive thinking patterns (especially where and when [“wherewhen”] combined with psychotherapy). The drug we are referring to is psilocybin, a naturally-occuring substance found in members of a variety of genera of mushrooms that include Psilocybe, Panaeolus, Gymnopilus, and others. The most commonly cultivated and utilized species of the genus Psilocybe is cubensis (Psilocybe cubensis).
These types of mushrooms are colloquially referred to as "magic mushrooms", but there is nothing really nothing magical about them. Psilocybin, contained in these mushrooms, however, provides several benefits to those who consume it in the right ways. Soon, we will explain the recommended dosages and the benefits that they have been proven by scientific researchers to provide. Check back soon to obtain that information in this page of our website.